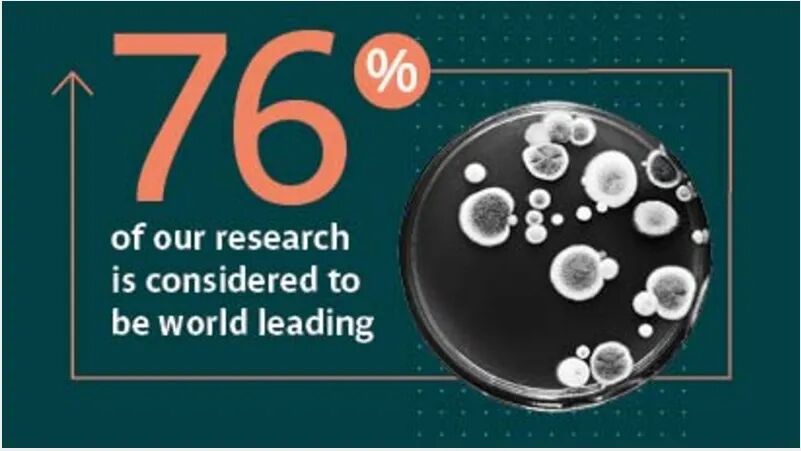
图片

英国
3年本科学制、1-2年硕士学制
名校众多、教学质量优良
一直是中国留学生的热门选择
广州城理众多学子心仪的英国学府
今天来看
英国西英格兰大学
(University of the West of England)

3+1本硕连读项目
(2026年秋季入学)

【对接专业】
国际经济与贸易(双语特色班)
会计学(ACCA审计双语班)
会计学(注册会计师双语班)
投资学
商务英语
英语
【申请对象】
国际商学院、外国语学院大三学生
【项目优势】
• 学生可用4年时间获得本科和硕士学位,降低时间和经济成本
• 毕业后可获得两年Post Study Work签证
• 西英获卓越教学框架金奖,教学质量优良
• 英国最大商学院之一,实习实践机会丰富
• 可接受语言内测,通过内测可以免考雅思
• 商科就业率92%
入学要求

【基本要求】
• 在校平均成绩达70分(百分制)以上;
• 雅思或者内部语言测试成绩总分5.0且单项不低于4.5,即可修读语言衔接课程;
(雅思总分6.5且单项不低于5.5、或通过内部语言测试的,可直接进入硕士专业课学习)
【语言衔接课程】
• 可线上修读,与广城理正常课程同步进行
• 每年5月上旬开课,最长12周

奖学金与参考费用

• 西英格兰大学奖学金(以下二选一):
(1)合作院校奖学金:£1,000
(2)优秀学生奖学金:£2,000-8,000,语言与学业成绩达到直录要求
• 学费:£16750/学年,约合人民币¥160,000元/学年
• 生活费:约£12,000/学年,约合人民币¥115,000元/学年


学校介绍
• 西英格兰大学(University of the West of England,简称UWE)始建于1595年,是英国最大和最受欢迎的综合性大学之一,有3个校区,其中主校区为Frenchay Campus。在校学生超过30000人。
• 西英提供许多学科领域课程,如商科、计算机、工程和数学科学、应用科学、艺术传媒和设计、环境建筑、教育、语言和社会科学等。
• 我校与西英自2011年起开始合作,至今已有近百名学生参加创意学术竞赛、学期交换、2+2/3+1本科双学位、硕士等项目,而且两校教师交流密切。


2025年英国《卫报》西南地区排名#4


就业升学率为90%

76%的科研世界领先
布里斯托介绍
• 西英格兰大学位于布里斯托(Bristol)市中心,交通便利,距伦敦仅一个小时火车车程。
• 布里斯托是英国西南第二大城市,也是英格兰八大核心城市之一。
• 布里斯托是一座充满朝气的多元文化城市,国际气球节和风筝节、Banksy涂鸦画吸引了来自世界各地的游客。

项目学生剪影

冯同学
国际商学院2021级学生
2024年赴西英参加3+1本科双学位项目
英国利兹大学录取研究生

陈同学
国际商学院2019级学生
2022年赴西英参加3+1本科双学位项目
英国兰卡斯特大学录取研究生

夏同学
计算机工程学院2020级学生
2022年赴西英参加2+2本科双学位项目
西英格兰大学中国学生大使
澳大利亚墨尔本大学录取研究生

陈同学
管理学院2016级学生
2019年赴西英参加3+1双本项目
英国兰卡斯特大学录取研究生

如需咨询报名,请与我们联系:
联系人:江老师
地址:行政楼412办公室
电话:020-36903177
邮箱:international@gcu.edu.cn

图文 | 国际交流与合作处、英国西英格兰大学
编辑 | 江雨舟
初审 | 江雨舟
复审 | 蔡晓坤
审核 | 黄卉菁
2024 © 广州城市理工学院国际商学院 all rights reserved 粤ICP备16061513号